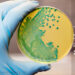
Melioidosis: Beban dan Kesedaran Penyakit di Malaysia

Oleh : Amin-Safwan Adnan, Irham Razak &Dzulhelmi Nasir
Bahagian Penyelidikan Biologi & Kelestarian MPOB, Wildlife Conservation Society

Malaysia merupakan sebuah negara yang kaya dengan sumber khazanah alam dan telah tersenarai sebagai salah sebuah dari 12 negara mega kepelbagaian biologi dunia. Hal ini kerana Malaysia mempunyai hutan tropika yang menjadi habitat bagi pelbagai spesies fauna. Hutan ini merupakan hutan yang paling luas dan terpenting di Malaysia (meliputi 70% kawasan hutan di Malaysia; 46% di Sarawak, 31% di Semenanjung Malaysia, dan 23% di Sabah). Hutan ini bersifat malar hijau, yang mana pokok-pokok tidak menggugurkan semua daun pada masa yang sama, tumbuhan rapat-rapat dan tebal, suhu yang stabil, mempunyai kadar hujan yang tinggi, serta mempunyai dua musim, iaitu hujan dan panas (Abrams & Abrams, 2019). Terdapat empat lapisan nyata kepada pembentukan hutan tropika (Zakaria et al., 2016; Rogers, 1999), iaitu; lapisan renjong atau emergen (>40 meter), lapisan konopi atau juga dikenali sebagai lapisan silara (20-40 meter), lapisan tengah (10-20 meter), dan lapisan bawah atau lantai (<10 meter). Setiap lapisan mempunyai ciri-ciri tersendiri, dan didiami oleh flora dan fauna mengikut spesifikasi dan kesesuaian terhadap habitat.

Pada lapisan renjong atau emergen, kebanyakkan fauna yang boleh didapati ialah burung-burung (contohnya: burung enggang, helang, dan kakak tua) serta mamalia seperti monyet dan kelawar, yang majoritinya memakan buah dan daun. Kebiasaannya, haiwan-haiwan yang berada di lapisan teratas ini jarang untuk turun ke lapisan yang lain. Namun begitu, terdapat hubung kait antara satu lapisan dan lapisan yang lain. Bagi mamalia yang berada di lapisan ini, kebiasaannya mereka bergerak dengan cara menggelosor (kebolehan menggunakan layar kulit) dan berpaut kepada daun-daun dan dahan pokok. Ini dapat dilihat pada tupai terbang dan kubung yang berkebolehan untuk meluncur sejauh 100 meter (Rogers, 1999), dan monyet yang bergayut dari satu dahan ke dahan yang lain. Selain itu, terdapat juga katak terbang, ular, dan serangga seperti lebah, kupu-kupu, rama-rama, dan semut. Burung dan serangga memainkan peranan yang penting sebagai ejen pendebungaan pada lapisan ini (Zakaria et al., 2016).
Artikel Berkaitan – Katak Sebagai Indikator Ekosistem Alam Yang Sihat
Artikel Berkaitan –Â Burung Nokturnal: Burung Hantu, Burung Tukang dan Burung Segan
Artikel Berkaitan –Â Mengenali dan Memahami Spesies Musang di Malaysia
Artikel Berkaitan –Â Burung Ciak Urasia Sebagai Biopenunjuk Kualiti Udara
Artikel Berkaitan –Â Peranan Semut Dalam Mengenali Pencipta
Artikel Berkaitan –Â Kepelbagaian Fungsi Artropoda
Artikel Berkaitan –Â Keunikan dua Primat Malam

Lapisan kedua, iaitu kanopi atau silara dikenali sebagai lapisan utama dalam ekosistem hutan tropika (Zakaria et al., 2016). Lapisan ini kaya dengan kepelbagaian sumber makanan dan merupakan habitat ideal bagi kepelbagaian spesies burung, mamalia, reptilia, amfibia, dan juga artropoda. Antara spesies haiwan yang boleh didapati di lapisan ini ialah burung enggang, tupai terbang, orang utan, ungka, kera, kongkang, kera hantu, lutung dan juga ular. Lebih daripada separuh spesies burung enggang berada di lapisan ini. Namun begitu, Burung Enggang Tebang Mentua (Buceros vigil) dan Burung Enggang Badak (Buceros rhinoceros) merupakan dua spesies yang paling mudah didapati terutamanya di Borneo dan dilindungi di negara kita.

Pada lapisan tengah, serangga seperti lebah, rama-rama, semut dan kumbang banyak didapati di lapisan ini. Serangga-serangga ini berfungsi di dalam rantaian makanan sebagai sumber makanan utama kepada pelbagai jenis burung dan reptilia. Selain itu, pelbagai spesies kelawar, monyet, ular, cicak, biawak, katak, musang, dan harimau bintang turut dijumpai di lapisan ini.
Lapisan lantai hutan merupakan lapisan yang kaya dengan bahan organik seperti daun, buah, dan dahan pokok yang jatuh dari lapisan-lapisan atas. Lapisan ini juga dipenuhi dengan kulat dan lumut. Pada lapisan ini, binatang seperti rusa, memerang, tenuk, landak, tenggiling, seladang, beruang, gajah, harimau, kucing hutan dan pelbagai spesies serangga boleh dijumpai. Selain itu, terdapat juga tupai, musang, babi, katak, ular, dan pelbagai spesies cicak boleh dijumpai di lantai hutan (Zakaria et al., 2016; Rogers, 1999).



Menurut Jabatan Penerangan Malaysia (2017), secara umumnya terdapat 480 mamalia, 242 amfibia, 567 reptilia, 1967 kupu-kupu, dan 1073 kumbang daun telah disenaraikan dalam hutan tropika Malaysia. Selain itu, sejumlah 600 lebih spesies burung telah direkodkan di Semenanjung Malaysia, dan 580 spesies di Borneo telah diklasifikasi dan dikenal pasti, lantas menandakan betapa kayanya Malaysia dengan khazanah fauna ini. Namun begitu, kajian dan spesifikasi yang lebih mendalam adalah diperlukan memandangkan kurangnya pengetahuan dan pendedahan terhadap lapisan-lapisan hutan ini dari semasa ke semasa. Sebagai cadangan, kajian-kajian pada masa hadapan boleh lebih fokus terhadap setiap lapisan hutan supaya spesifikasi fauna yang berada di lapisan itu dapat dikenal pasti secara keseluruhan, dan dipelajari sebaik mungkin bagi memelihara jumlah mereka agar tidak pupus ditelan zaman. Justeru itu, amat penting bagi kita memelihara khazanah negara ini supaya dapat dinikmati oleh generasi hadapan.
Rujukan
- Abrams, R.W., Abrams, J.F. (2019). Why Should We Care So Much About Old World Tropical Rainforest? In book: Reference Module in Earth Systems and Environmental Sciences.
- Jabatan Penerangan Malaysia (2017). Accessed from: Malaysia.gov.my/portal/content/143?language=my (8 April 2020).
- Rogers, L.J. (1999). Fauna: Past, Present and Future. In: Kaur, A., Metcalfe, I. (eds.). The Shaping of Malaysia. Studies in the Economies of East and South-East Asia. Palgrave Macmillan, London, UK.
- Zakaria, M., Rajpar, M.N., Ozdemir, I., Rosli, Z. (2016). Fauna Diversity in Tropical Rainforest: Threats from Land-Use Change. In: Blanco, J.A., Chang, S-C., Lo, Y-H. (eds.). Tropical Forests the Challenge of Monitoring Ecosystem Services while Managing the Landscape. INTECH, London, UK.
Kredit Foto : Amin-Safwan Adnan, Irham Razak &Dzulhelmi Nasir